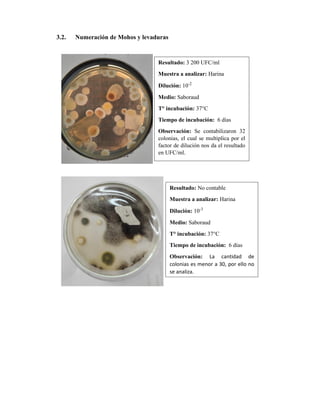
3.2. Numeración de Mohos y levaduras
Resultado: 3 200 UFC/ml
Muestra a analizar: Harina
Dilución: 10-2
Medio: Saboraud
T° incubación: 37°C
Tiempo de incubación: 6 días
Observación: Se contabilizaron 32
colonias, el cual se multiplica por el
factor de dilución nos da el resultado
en UFC/ml.
Resultado: No contable
Muestra a analizar: Harina
Dilución: 10-3
Medio: Saboraud
T° incubación: 37°C
Tiempo de incubación: 6 días
Observación: La cantidad de
colonias es menor a 30, por ello no
se analiza.

Este documento presenta los resultados de un estudio microbiológico de la harina de trigo realizado por estudiantes de la Universidad Nacional de Piura. Se evaluó la presencia de Enterobacteriaceae, mohos y levaduras, y Salmonella. Los resultados mostraron que la harina tenía 3,200 UFC/ml de mohos y levaduras, pero fue negativa para Enterobacteriaceae y Salmonella.

![VI. REFERENCIAS BIBLIOGRAFICAS
Alessi, P. A., & Ekmeiro, J. E. (2020). Inocuidad microbiológica de las masas artesanales de maíz
expendidas en Puerto La Cruz, Venezuela. Revista Peruana de Investigación en Salud, 4(4), 161-
169.
Bio Rad. (2019). Sabouraud chloramphenicol agar. Francia.
Carrillo, L., Audisio, M. C., Bejarano, N., Gómez, S., Ancasi, G., & Benítez, M. (2007). Manual de
Microbiología de los Alimentos. Jujuy, 10, 102-116.
Delgadillo, J. R. (2018). Parámetros físico-químicos y microbiológicos de los productos de panificación y
galletería elaborados con harina producida con banano orgánico de descarte. [Tesis de pregrado,
Universidad César Vallejo].
Herrera, A., & Peña, M. (2006). Análisis Fisicoquímico y Microbiológico de las harinas de trigo producidas
en el salvador. Trabajo de graduación. Lic. FQF San Salvador, El Salvador. Universidad de El
Salvador. 10p.
Jay, J. M., Loessner, M. J., & Golden, D. A. (2008). Modern food microbiology. Springer Science &
Business Media.
Osorio, J., Ramirez, I., Gayoso, A., Fernández, D., Benitez, C., Martínez, I., Arrúa , A. (2015). Detección
e identificación de hongos en harina de trigo de consumohumano y cuantificación de
deoxinivalenol. Paraguay: Stevia.
Philip T F, Lienau Andrew H, Leung S C, Mui L A, Florence H, Bohnert M, Mooijman K. et al. Detection
of Salmonella in Fresh Cheese, Poultry Products, and Dried Egg Products by the ISO 6579
Salmonella Culture Procedure and the AOAC Official Method: Collaborative Study. J. AOAC Int.
2003; (86): 275-295.
Valenzuela, A., Llanos, Z., Osorio, S., & Azabache, N. (2001). Manual de Analisis Microbiologico de
Alimentos. Manual. Lima: Direccion General de Salud Ambiental (DIGESA), Lima.](https://image.slidesharecdn.com/informe7-micro-240119222635-8de24dd3/85/INFORME-7-MICRO-ALIMENTOS-pdf-8-320.jpg)
